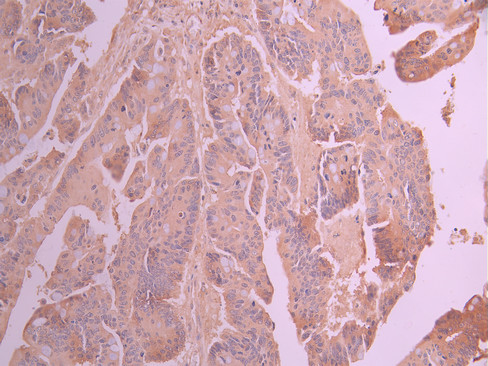

ULK3 Recombinant Monoclonal Antibody
-
中文名稱:ULK3 Recombinant Monoclonal Antibody
-
貨號:CSB-RA969203A0HU
-
規格:¥1320
-
圖片:
-
IHC image of CSB-RA969203A0HU diluted at 1:100 and staining in paraffin-embedded human colorectal cancer performed on a Leica BondTM system. After dewaxing and hydration, antigen retrieval was mediated by high pressure in a citrate buffer (pH 6.0). Section was blocked with 10% normal goat serum 30min at RT. Then primary antibody (1% BSA) was incubated at 4°C overnight. The primary is detected by a Goat anti-rabbit polymer IgG labeled by HRP and visualized using 0.05% DAB.
-
IHC image of CSB-RA969203A0HU diluted at 1:100 and staining in paraffin-embedded human stomach tissue performed on a Leica BondTM system. After dewaxing and hydration, antigen retrieval was mediated by high pressure in a citrate buffer (pH 6.0). Section was blocked with 10% normal goat serum 30min at RT. Then primary antibody (1% BSA) was incubated at 4°C overnight. The primary is detected by a Goat anti-rabbit polymer IgG labeled by HRP and visualized using 0.05% DAB.
-
Immunofluorescence staining of Hela cell with CSB-RA969203A0HU at 1:50, counter-stained with DAPI. The cells were fixed in 4% formaldehyde, permeabilized using 0.2% Triton X-100 and blocked in 10% normal Goat Serum. The cells were then incubated with the antibody overnight at 4°C. The secondary antibody was Alexa Fluor 488-congugated AffiniPure Goat Anti-Rabbit IgG(H+L).
-
Overlay Peak curve showing PC-3 cells stained with CSB-RA969203A0HU (red line) at 1:100. The cells were fixed in 4% formaldehyde and permeated by 0.2% TritonX-100 for 10min. Then 10% normal goat serum to block non-specific protein-protein interactions followed by the antibody (1ug/1*106cells) for 45min at 4℃. The secondary antibody used was FITC-conjugated goat anti-rabbit IgG (H+L) at 1/200 dilution for 35min at 4℃.Control antibody (green line) was Rabbit IgG (1ug/1*106cells) used under the same conditions. Acquisition of >10,000 events was performed.
-
-
其他:
產品詳情
-
Uniprot No.:
-
基因名:ULK3
-
別名:Serine/threonine-protein kinase ULK3 (EC 2.7.11.1) (Unc-51-like kinase 3), ULK3
-
反應種屬:Human
-
免疫原:A synthesized peptide from human ULK3 protein
-
免疫原種屬:Homo sapiens (Human)
-
標記方式:Non-conjugated
-
克隆類型:Monoclonal
-
抗體亞型:Rabbit IgG
-
純化方式:Affinity-chromatography
-
克隆號:4D2
-
濃度:It differs from different batches. Please contact us to confirm it.
-
保存緩沖液:Preservative: 0.03% Proclin 300
Constituents: 50% Glycerol, 0.01M PBS, PH 7.4 -
產品提供形式:Liquid
-
應用范圍:ELISA, IHC, IF, FC
-
推薦稀釋比:
Application Recommended Dilution IHC 1:50-1:200 IF 1:50-1:200 FC 1:50-1:200 -
Protocols:
-
儲存條件:Upon receipt, store at -20°C or -80°C. Avoid repeated freeze.
-
貨期:Basically, we can dispatch the products out in 1-3 working days after receiving your orders. Delivery time maybe differs from different purchasing way or location, please kindly consult your local distributors for specific delivery time.
-
用途:For Research Use Only. Not for use in diagnostic or therapeutic procedures.
相關產品
靶點詳情
-
功能:Serine/threonine protein kinase that acts as a regulator of Sonic hedgehog (SHH) signaling and autophagy. Acts as a negative regulator of SHH signaling in the absence of SHH ligand: interacts with SUFU, thereby inactivating the protein kinase activity and preventing phosphorylation of GLI proteins (GLI1, GLI2 and/or GLI3). Positively regulates SHH signaling in the presence of SHH: dissociates from SUFU, autophosphorylates and mediates phosphorylation of GLI2, activating it and promoting its nuclear translocation. Phosphorylates in vitro GLI2, as well as GLI1 and GLI3, although less efficiently. Also acts as a regulator of autophagy: following cellular senescence, able to induce autophagy.
-
基因功能參考文獻:
- Increased ULK3 also induces autophagy, which is unlinked from GLI and CAF activation. ULK3 upregulation occurs in the CAFs of several tumor types, and ULK3 silencing suppresses the tumor-enhancing properties of these cells. PMID: 28877478
- Structural and biochemical studies reveal an unusually tight interaction between ULK3 and IST1, an ESCRT-III subunit required for cytokinetic abscission. PMID: 26011858
- First named and identified as protein kinase of the ULK family PMID: 12471243
- Dual function of UNC-51-like kinase 3 (Ulk3) in the Sonic hedgehog signaling pathway. PMID: 20643644
- serine/threonine kinase ULK3 is involved in the SHH pathway as a positive regulator of GLI proteins PMID: 19878745
顯示更多
收起更多
-
亞細胞定位:Cytoplasm. Note=Localizes to pre-autophagosomal structure during cellular senescence.
-
蛋白家族:Protein kinase superfamily, Ser/Thr protein kinase family, APG1/unc-51/ULK1 subfamily
-
組織特異性:Widely expressed. Highest levels observed in fetal brain. In adult tissues, high levels in brain, liver and kidney, moderate levels in testis and adrenal gland and low levels in heart, lung, stomach, thymus, prostate and placenta. In the brain, highest ex
-
數據庫鏈接:
Most popular with customers
-
-
YWHAB Recombinant Monoclonal Antibody
Applications: ELISA, WB, IHC, IF, FC
Species Reactivity: Human, Mouse, Rat
-
-
-
-
-
-